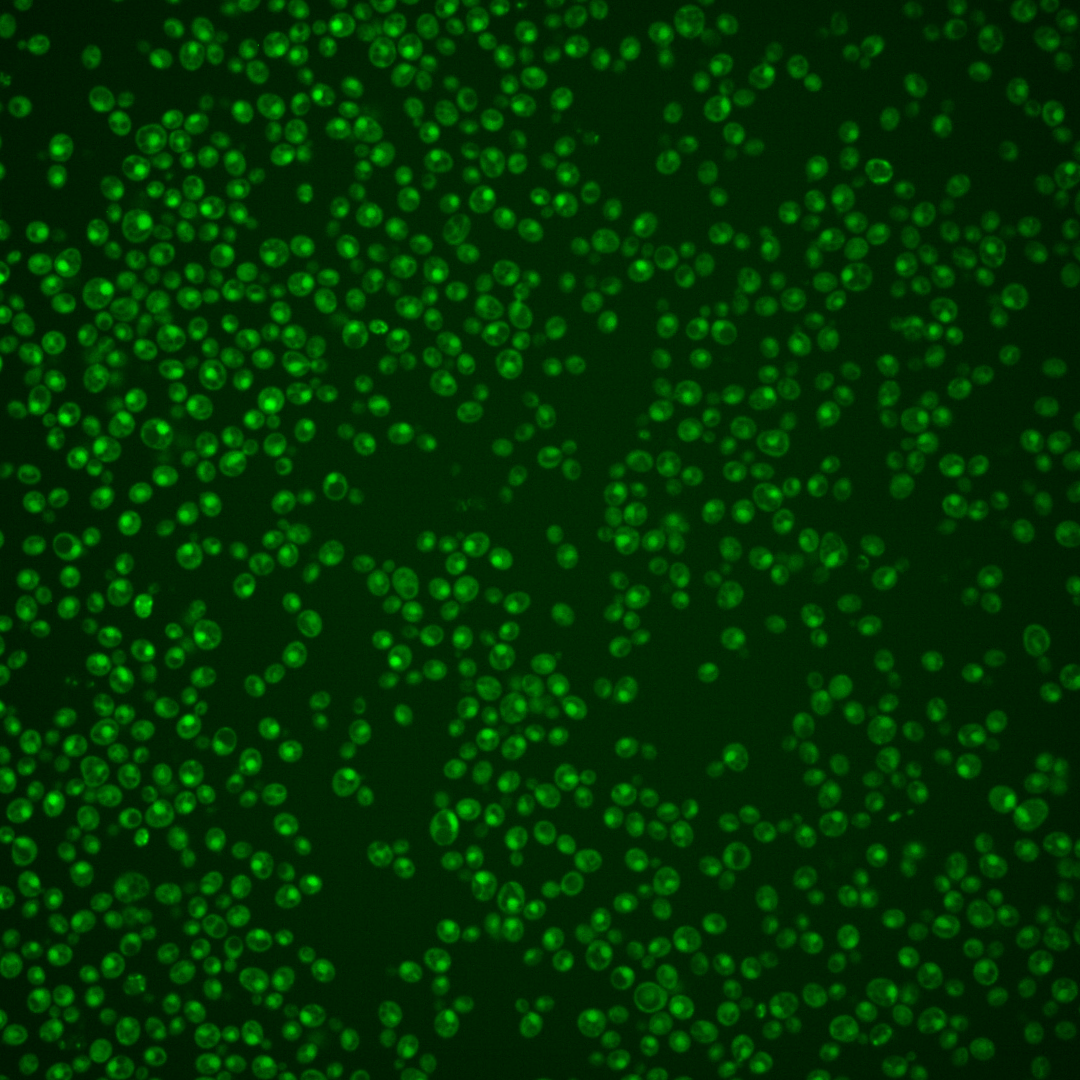
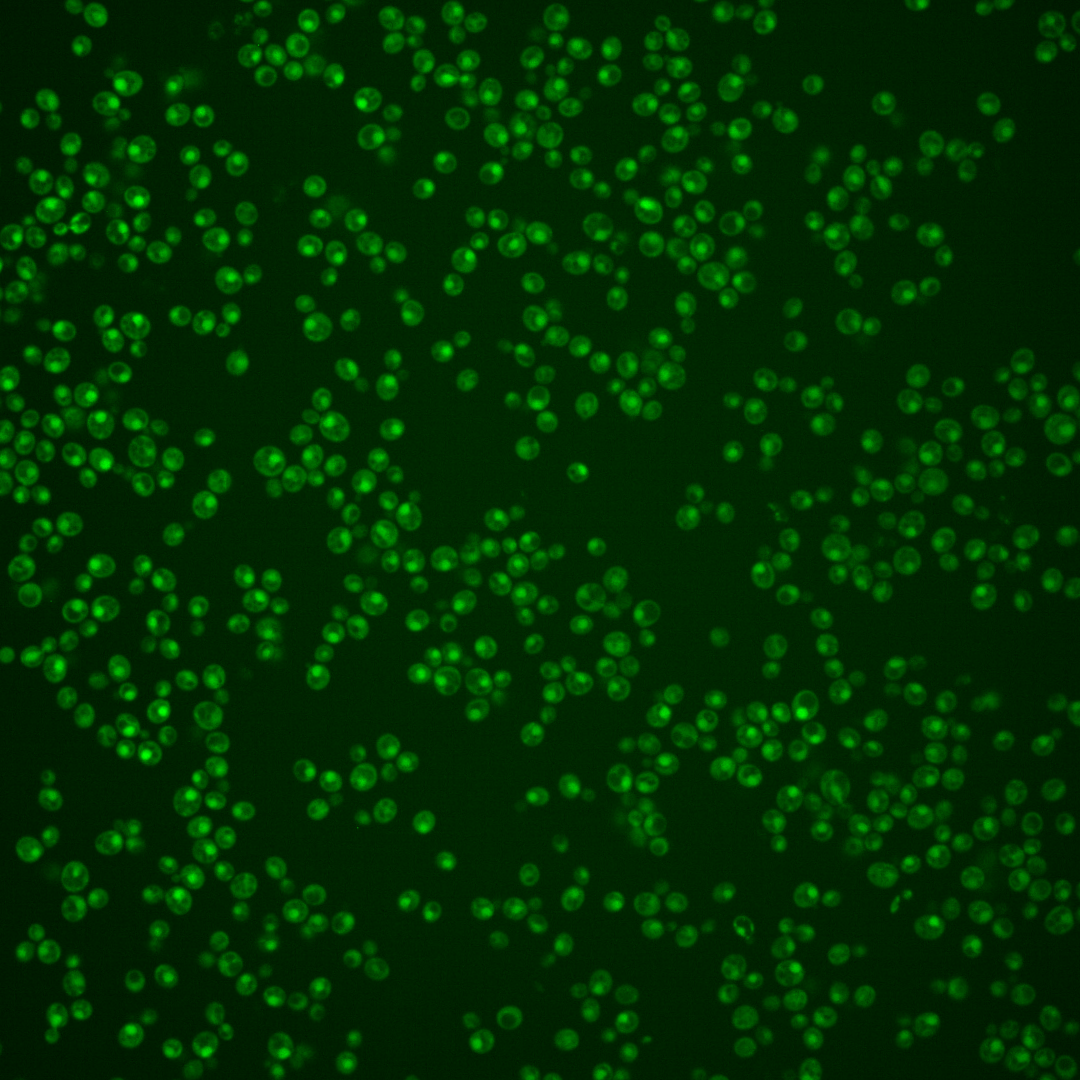
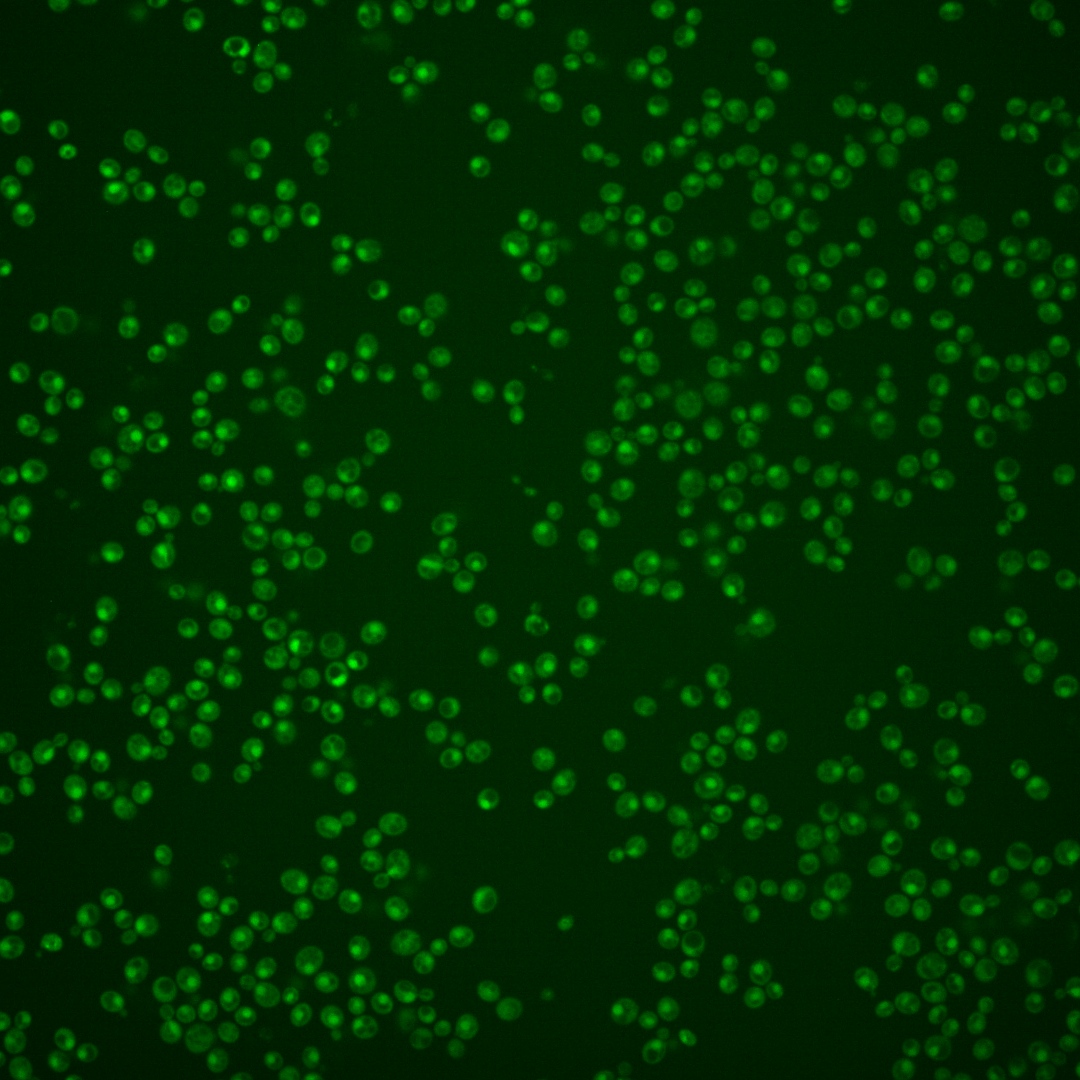
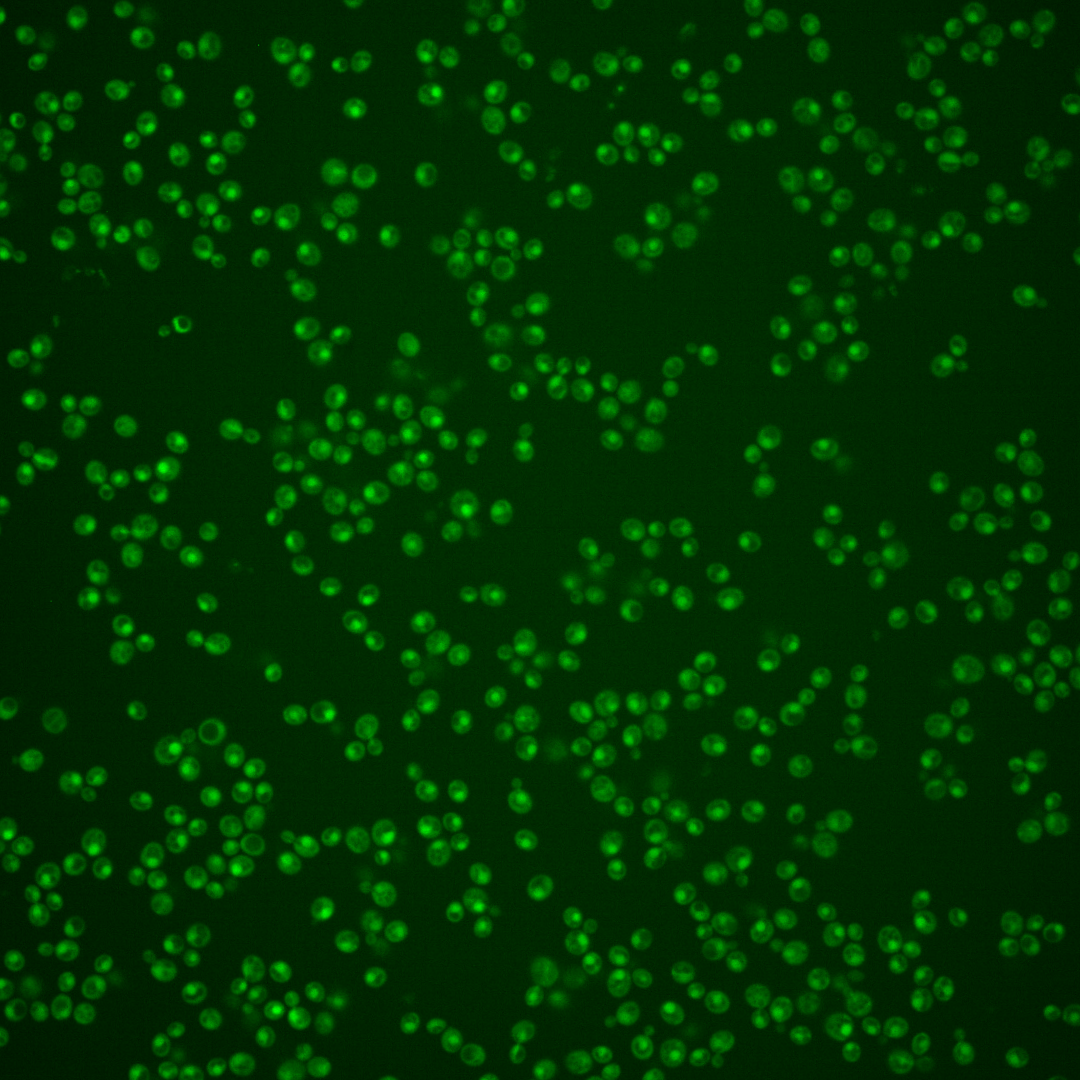
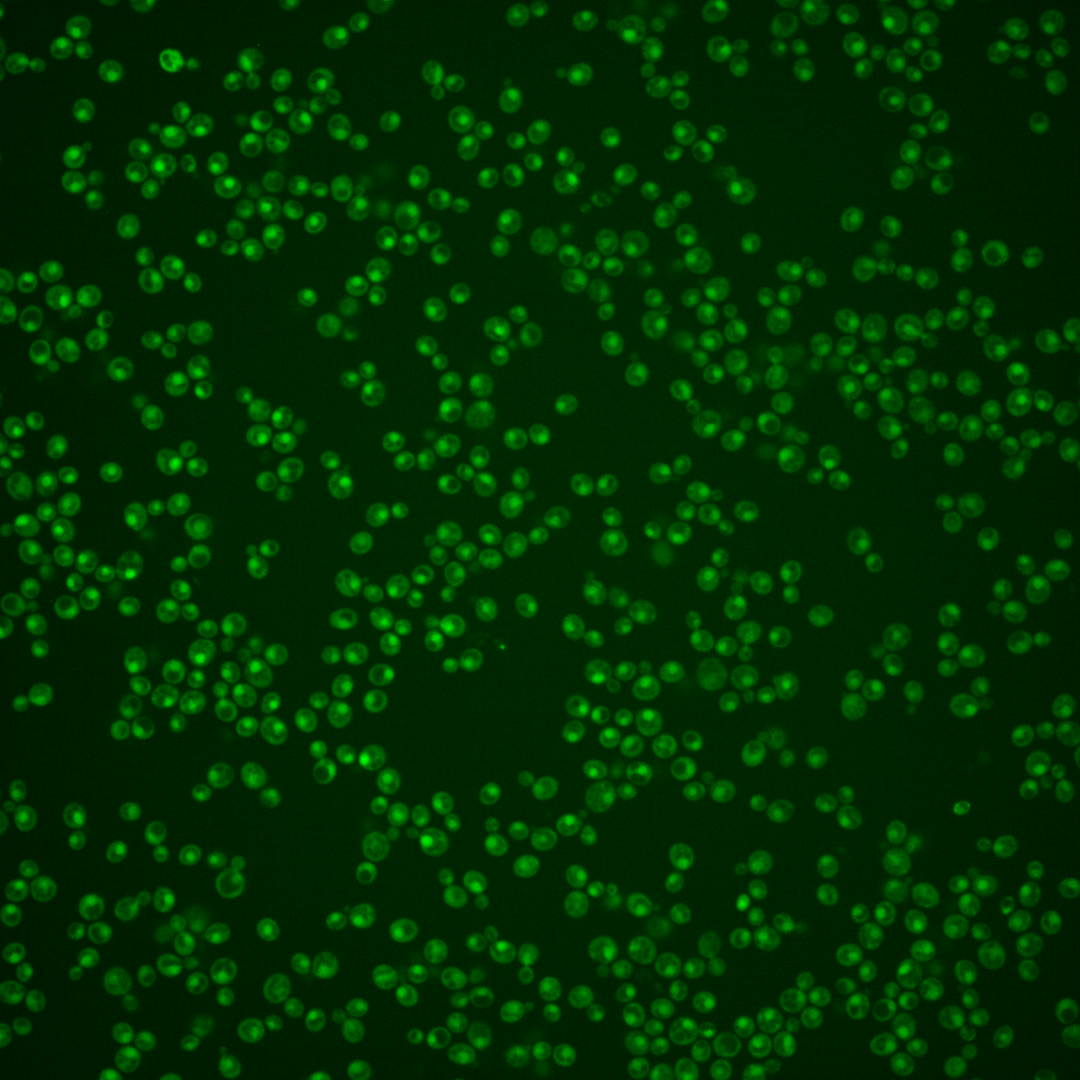

| Standard name | |
|---|---|
| Human Ortholog | |
| Description | Transcription factor involved in sulfite metabolism; sole identified regulatory target is SSU1; overexpression suppresses sulfite-sensitivity of many unrelated mutants due to hyperactivation of SSU1, contains five zinc fingers; protein abundance increases in response to DNA replication stress |
Micrographs




















































































Sub-cellular Localization
Yeast GFP Assignment
Protein Abundance
Localization Change
External localization resources
| ensLOC | DeepLoc | |||||||||||||||||||||||
|---|---|---|---|---|---|---|---|---|---|---|---|---|---|---|---|---|---|---|---|---|---|---|---|---|
| Localization | WT1 | WT2 | WT3 | RAP60 | RAP140 | RAP220 | RAP300 | RAP380 | RAP460 | RAP540 | RAP620 | RAP700 | HU80 | HU120 | HU160 | rpd3Δ_1 | rpd3Δ_2 | rpd3Δ_3 | WT1 | WT2 | WT3 | AF100 | AF140 | AF180 |
| Cortical Patches | 0 | 0 | 0 | 0 | 0 | 0 | 0 | 0 | 0 | 0 | 0 | 0 | 0 | 0 | 0 | 0 | 0 | 0 | 0 | 0 | 1 | 0 | 0 | 1 |
| Bud | 0 | 0 | 0 | 0 | 0 | 0 | 1 | 1 | 3 | 2 | 4 | 5 | 0 | 0 | 0 | 0 | 0 | 0 | 10 | 7 | 2 | 0 | 3 | 7 |
| Bud Neck | 0 | 0 | 0 | 0 | 0 | 0 | 0 | 4 | 3 | 1 | 2 | 0 | 0 | 0 | 0 | 0 | 0 | 0 | 0 | 1 | 0 | 0 | 0 | 1 |
| Bud Site | 0 | 0 | 0 | 0 | 0 | 0 | 0 | 0 | 2 | 2 | 2 | 1 | 0 | 0 | 0 | 0 | 0 | 0 | – | – | – | – | – | – |
| Cell Periphery | 0 | 0 | 0 | 0 | 0 | 0 | 0 | 0 | 0 | 0 | 0 | 0 | 0 | 0 | 0 | 0 | 0 | 0 | 0 | 0 | 0 | 0 | 0 | 0 |
| Cytoplasm | 29 | 38 | 17 | 17 | 30 | 21 | 44 | 35 | 41 | 29 | 20 | 15 | 19 | 28 | 60 | 24 | 20 | 21 | 14 | 26 | 6 | 14 | 32 | 26 |
| Endoplasmic Reticulum | 1 | 1 | 1 | 0 | 1 | 0 | 0 | 1 | 0 | 0 | 0 | 0 | 0 | 3 | 1 | 8 | 7 | 5 | 0 | 0 | 0 | 0 | 1 | 1 |
| Endosome | 0 | 1 | 2 | 2 | 6 | 1 | 2 | 4 | 0 | 0 | 0 | 1 | 3 | 0 | 1 | 2 | 3 | 0 | 2 | 2 | 1 | 1 | 2 | 2 |
| Golgi | 0 | 0 | 0 | 0 | 0 | 0 | 0 | 0 | 0 | 0 | 0 | 0 | 0 | 0 | 0 | 0 | 0 | 0 | 3 | 1 | 0 | 0 | 0 | 0 |
| Mitochondria | 2 | 66 | 0 | 12 | 2 | 30 | 44 | 64 | 226 | 119 | 99 | 143 | 3 | 0 | 2 | 8 | 7 | 1 | 0 | 5 | 1 | 0 | 1 | 4 |
| Nucleus | 242 | 287 | 158 | 150 | 176 | 220 | 241 | 314 | 232 | 255 | 169 | 173 | 107 | 159 | 156 | 63 | 90 | 92 | 251 | 328 | 164 | 58 | 132 | 130 |
| Nuclear Periphery | 0 | 0 | 0 | 0 | 0 | 0 | 0 | 0 | 0 | 1 | 0 | 0 | 0 | 0 | 0 | 0 | 0 | 0 | 0 | 0 | 0 | 0 | 2 | 0 |
| Nucleolus | 0 | 1 | 0 | 0 | 2 | 0 | 2 | 1 | 1 | 0 | 0 | 4 | 0 | 0 | 0 | 0 | 0 | 0 | 0 | 0 | 0 | 0 | 3 | 4 |
| Peroxisomes | 0 | 0 | 1 | 0 | 0 | 0 | 1 | 0 | 0 | 0 | 0 | 0 | 0 | 0 | 0 | 0 | 0 | 0 | 0 | 0 | 0 | 0 | 0 | 0 |
| SpindlePole | 0 | 0 | 0 | 2 | 1 | 0 | 1 | 4 | 1 | 6 | 0 | 3 | 1 | 0 | 0 | 1 | 0 | 0 | 8 | 9 | 3 | 2 | 5 | 9 |
| Vac/Vac Membrane | 59 | 59 | 12 | 10 | 17 | 18 | 21 | 32 | 21 | 25 | 21 | 27 | 23 | 15 | 21 | 35 | 53 | 29 | 31 | 62 | 23 | 14 | 40 | 58 |
| Unique Cell Count | 303 | 387 | 184 | 182 | 225 | 268 | 330 | 417 | 382 | 361 | 246 | 276 | 142 | 193 | 229 | 118 | 151 | 132 | 326 | 453 | 208 | 94 | 236 | 256 |
| Labelled Cell Count | 333 | 453 | 191 | 193 | 235 | 290 | 357 | 460 | 530 | 440 | 317 | 372 | 156 | 205 | 241 | 141 | 180 | 148 | 326 | 453 | 208 | 94 | 236 | 256 |
Yeast GFP Assignment
Protein Abundance
| Screen | WT1 | WT2 | WT3 | RAP60 | RAP140 | RAP220 | RAP300 | RAP380 | RAP460 | RAP540 | RAP620 | RAP700 | HU80 | HU120 | HU160 | rpd3Δ_1 | rpd3Δ_2 | rpd3Δ_3 | AF100 | AF140 | AF180 |
|---|---|---|---|---|---|---|---|---|---|---|---|---|---|---|---|---|---|---|---|---|---|
| Mean Cell GFP Intensity (1e-4) | 5.5 | 4.4 | 6.2 | 5.7 | 6.2 | 5.1 | 4.9 | 5.1 | 4.0 | 4.4 | 4.4 | 4.2 | 5.8 | 5.9 | 5.4 | 5.3 | 6.4 | 6.8 | 6.6 | 6.5 | 6.3 |
| Std Deviation (1e-4) | 0.8 | 0.8 | 1.2 | 1.2 | 1.3 | 1.2 | 1.3 | 1.2 | 0.8 | 0.7 | 0.9 | 1.0 | 1.1 | 0.8 | 1.1 | 1.4 | 1.1 | 1.5 | 1.7 | 1.7 | 1.6 |
| Intensity Change (Log2) | – | – | – | -0.13 | 0.0 | -0.28 | -0.34 | -0.27 | -0.64 | -0.5 | -0.5 | -0.55 | -0.09 | -0.08 | -0.19 | -0.23 | 0.04 | 0.13 | 0.08 | 0.07 | 0.03 |
Localization Change
| Localization | RAP60 | RAP140 | RAP220 | RAP300 | RAP380 | RAP460 | RAP540 | RAP620 | RAP700 | HU80 | HU120 | HU160 | rpd3Δ_1 | rpd3Δ_2 | rpd3Δ_3 |
|---|---|---|---|---|---|---|---|---|---|---|---|---|---|---|---|
| Actin | – | – | – | – | – | – | – | – | – | – | – | – | – | – | – |
| Bud | – | – | – | – | – | – | – | – | – | – | – | – | 0 | 0 | 0 |
| Bud Neck | – | – | – | – | – | – | – | – | – | – | – | – | 0 | 0 | 0 |
| Bud Site | – | – | – | – | – | – | – | – | – | – | – | – | 0 | 0 | 0 |
| Cell Periphery | – | – | – | – | – | – | – | – | – | – | – | – | 0 | 0 | 0 |
| Cyto | – | – | – | – | – | – | – | – | – | – | – | – | – | – | – |
| Endoplasmic Reticulum | – | – | – | – | – | – | – | – | – | – | – | – | 0 | 0 | 0 |
| Endosome | – | – | – | – | – | – | – | – | – | – | – | – | 0 | 0 | 0 |
| Golgi | – | – | – | – | – | – | – | – | – | – | – | – | 0 | 0 | 0 |
| Mitochondria | – | – | – | – | – | – | – | – | – | – | – | – | 0 | 0 | 0 |
| Nuclear Periphery | – | – | – | – | – | – | – | – | – | – | – | – | 0 | 0 | 0 |
| Nuc | – | – | – | – | – | – | – | – | – | – | – | – | – | – | – |
| Nucleolus | – | – | – | – | – | – | – | – | – | – | – | – | 0 | 0 | 0 |
| Peroxisomes | – | – | – | – | – | – | – | – | – | – | – | – | 0 | 0 | 0 |
| SpindlePole | – | – | – | – | – | – | – | – | – | – | – | – | 0 | 0 | 0 |
| Vac | – | – | – | – | – | – | – | – | – | – | – | – | – | – | – |
| Cortical Patches | – | – | – | – | – | – | – | – | – | – | – | – | 0 | 0 | 0 |
| Cytoplasm | – | – | – | – | – | – | – | – | – | – | – | – | 0 | 0 | 0 |
| Nucleus | – | – | – | – | – | – | – | – | – | – | – | – | 0 | 0 | 0 |
| Vacuole | – | – | – | – | – | – | – | – | – | – | – | – | 5.4 | 6.6 | 4.0 |
External localization resources
Images






























Protein Concentration and Protein Localization Data
| R1 | R2 | R3 | ||||||||||||||||
|---|---|---|---|---|---|---|---|---|---|---|---|---|---|---|---|---|---|---|
| G1 Pre-START | G1 Post-START | S/G2 | Metaphase | Anaphase | Telophase | G1 Pre-START | G1 Post-START | S/G2 | Metaphase | Anaphase | Telophase | G1 Pre-START | G1 Post-START | S/G2 | Metaphase | Anaphase | Telophase | |
| Concentration | 2.9015 | 3.4338 | 3.4556 | 2.7346 | 2.734 | 2.8927 | 4.9487 | 4.2218 | 4.4209 | 4.8104 | 4.4695 | 4.3635 | 1.9413 | 2.2686 | 2.1829 | 1.9453 | 1.7279 | 2.3195 |
| Actin | 0.0102 | 0.0001 | 0.0298 | 0.0435 | 0.0001 | 0.0001 | 0.0251 | 0.0002 | 0.0003 | 0.0139 | 0.0013 | 0.0006 | 0.1173 | 0.0003 | 0.011 | 0.0413 | 0.0001 | 0.0124 |
| Bud | 0.0003 | 0.0001 | 0.0003 | 0.0005 | 0.0004 | 0.0002 | 0.0011 | 0.0001 | 0.0001 | 0.0003 | 0.0002 | 0 | 0.0012 | 0.0001 | 0.0001 | 0.0006 | 0 | 0.0001 |
| Bud Neck | 0.0017 | 0.0004 | 0.002 | 0.0002 | 0.0036 | 0.0024 | 0.0018 | 0.0006 | 0.0001 | 0.0004 | 0.0004 | 0.001 | 0.0176 | 0.0003 | 0.0004 | 0.0016 | 0.0007 | 0.0014 |
| Bud Periphery | 0.0008 | 0 | 0.0003 | 0.001 | 0.0004 | 0.0002 | 0.0061 | 0.0001 | 0.0002 | 0.0003 | 0.0001 | 0 | 0.0021 | 0.0001 | 0.0001 | 0.0016 | 0 | 0.0002 |
| Bud Site | 0.0024 | 0.0005 | 0.0125 | 0.0012 | 0.0083 | 0.0002 | 0.0014 | 0.0061 | 0.0003 | 0.0137 | 0.0003 | 0.0001 | 0.0077 | 0.0006 | 0.0006 | 0.0018 | 0.0002 | 0.0001 |
| Cell Periphery | 0.0004 | 0.0001 | 0.0002 | 0.0001 | 0.0003 | 0 | 0.0017 | 0.0003 | 0.0001 | 0.0004 | 0 | 0 | 0.0008 | 0 | 0.0001 | 0.0003 | 0 | 0 |
| Cytoplasm | 0.0192 | 0.0438 | 0.0163 | 0.0128 | 0.0113 | 0.0212 | 0.0154 | 0.1567 | 0.0434 | 0.0547 | 0.1485 | 0.0177 | 0.026 | 0.0401 | 0.0198 | 0.0275 | 0.0158 | 0.0063 |
| Cytoplasmic Foci | 0.0155 | 0.0003 | 0.009 | 0.0008 | 0.0434 | 0.0001 | 0.0179 | 0.0006 | 0.0008 | 0.0044 | 0.0027 | 0.0004 | 0.0155 | 0.0008 | 0.0072 | 0.0036 | 0.0005 | 0.002 |
| Eisosomes | 0.0001 | 0 | 0.0001 | 0.0002 | 0 | 0 | 0.0006 | 0 | 0.0001 | 0.0002 | 0 | 0 | 0.0008 | 0 | 0.0001 | 0.0005 | 0 | 0 |
| Endoplasmic Reticulum | 0.0028 | 0.0019 | 0.0026 | 0.0008 | 0.0019 | 0.0004 | 0.0051 | 0.0054 | 0.0034 | 0.0065 | 0.0045 | 0.0006 | 0.0062 | 0.002 | 0.001 | 0.0013 | 0.0003 | 0.0017 |
| Endosome | 0.0106 | 0.0009 | 0.014 | 0.0056 | 0.0317 | 0.0008 | 0.0262 | 0.0017 | 0.0014 | 0.0037 | 0.0067 | 0.0012 | 0.015 | 0.0009 | 0.0018 | 0.0045 | 0.0006 | 0.0077 |
| Golgi | 0.0051 | 0 | 0.0066 | 0.0026 | 0.004 | 0 | 0.0228 | 0 | 0.0002 | 0.0013 | 0.0004 | 0.0001 | 0.0073 | 0 | 0.0015 | 0.0021 | 0 | 0.0045 |
| Lipid Particles | 0.0126 | 0 | 0.004 | 0.0052 | 0.024 | 0 | 0.0115 | 0.0001 | 0.0003 | 0.0007 | 0.0001 | 0.0001 | 0.0154 | 0.0002 | 0.0053 | 0.0115 | 0 | 0.0025 |
| Mitochondria | 0.0099 | 0.0002 | 0.0039 | 0.0169 | 0.0016 | 0.0009 | 0.0448 | 0.0006 | 0.0019 | 0.0011 | 0.0007 | 0.0002 | 0.0039 | 0.0002 | 0.001 | 0.0049 | 0.0002 | 0.008 |
| None | 0.0181 | 0.0113 | 0.0101 | 0.0358 | 0.0007 | 0.0003 | 0.0961 | 0.0188 | 0.0728 | 0.099 | 0.0961 | 0.026 | 0.0325 | 0.0462 | 0.0253 | 0.0608 | 0.0133 | 0.0183 |
| Nuclear Periphery | 0.0106 | 0.012 | 0.0065 | 0.0059 | 0.0088 | 0.0037 | 0.0392 | 0.0423 | 0.0094 | 0.0067 | 0.0195 | 0.0113 | 0.0147 | 0.0109 | 0.0052 | 0.0078 | 0.0041 | 0.0206 |
| Nucleolus | 0.0045 | 0.0033 | 0.0036 | 0.0021 | 0.0129 | 0.005 | 0.0058 | 0.0046 | 0.0023 | 0.0031 | 0.0021 | 0.0045 | 0.0073 | 0.0026 | 0.0023 | 0.0087 | 0.0046 | 0.0033 |
| Nucleus | 0.8237 | 0.918 | 0.8662 | 0.857 | 0.8196 | 0.9594 | 0.6196 | 0.7502 | 0.8595 | 0.7805 | 0.7053 | 0.9216 | 0.6436 | 0.8862 | 0.9016 | 0.8023 | 0.942 | 0.9001 |
| Peroxisomes | 0.0227 | 0 | 0.0068 | 0.0008 | 0.0083 | 0 | 0.0025 | 0 | 0.0001 | 0.0005 | 0.0001 | 0 | 0.0339 | 0 | 0.0101 | 0.0048 | 0 | 0.0048 |
| Punctate Nuclear | 0.0212 | 0.0051 | 0.0032 | 0.004 | 0.0033 | 0.0017 | 0.0349 | 0.0074 | 0.0019 | 0.0077 | 0.0092 | 0.0141 | 0.0282 | 0.0069 | 0.0043 | 0.0103 | 0.0169 | 0.0046 |
| Vacuole | 0.0064 | 0.0017 | 0.0017 | 0.0013 | 0.0141 | 0.0027 | 0.0114 | 0.0035 | 0.0011 | 0.0007 | 0.0011 | 0.0003 | 0.0025 | 0.0012 | 0.0012 | 0.0015 | 0.0006 | 0.0005 |
| Vacuole Periphery | 0.0011 | 0.0002 | 0.0004 | 0.0016 | 0.0011 | 0.0008 | 0.009 | 0.0006 | 0.0004 | 0.0002 | 0.0005 | 0.0001 | 0.0007 | 0.0002 | 0.0001 | 0.0006 | 0.0001 | 0.0008 |
Sequencing Data
| R1 | R2 | |||||||||
|---|---|---|---|---|---|---|---|---|---|---|
| G1 Post-START | S/G2 | Metaphase | Anaphase | Telophase | G1 Post-START | S/G2 | Metaphase | Anaphase | Telophase | |
| Gene Expression | 11.034 | 14.2477 | 13.8254 | 11.6754 | 9.5374 | 15.9292 | 11.9125 | 12.7146 | 11.7122 | 14.4049 |
| Translational Efficiency | 1.6033 | 1.1536 | 1.0509 | 1.2467 | 1.9777 | 1.2013 | 1.276 | 1.4659 | 1.5437 | 1.3863 |
Hit Data
| Dataset | Hit |
|---|---|
| Protein Concentration | ✘ |
| Protein Localization | ✘ |
| Gene Expression | ✘ |
| Translational Efficiency | ✘ |
Endocytosis
| Temp | Actin Patch (Sac6-tdTomato) | Cortical Patch (Sla1-GFP) | Late Endosome (Snf7-GFP) | Vacuole (Vph1-GFP) |
|---|---|---|---|---|
| 37℃ | ||||
| RT |
Cell Cycle Omics
CYCLoPs (Fzf1-GFP)
| Gene / Allele | Actin Patch (Sac6-tdTomato) | Cortical Patch (Sla1-GFP) | Late Endosome (Snf7-GFP) | Vacuole (Sac6-tdTomato) |
|---|
| Gene | Images |
|---|
| Gene | Images |
|---|
Images are not yet available
Images are not yet available